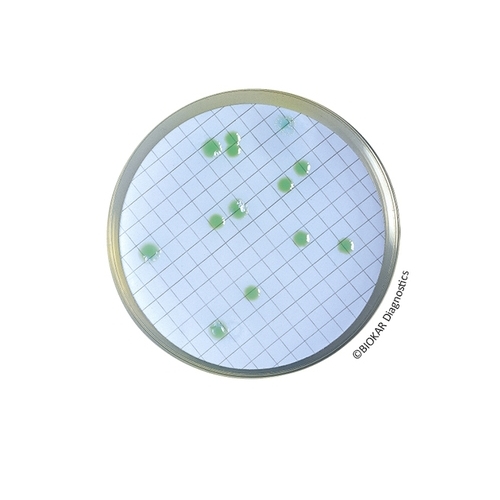
CN Agar For Pseudomonas

CN Agar For Pseudomonas
CN Agar for Pseudomonas is a selective medium for the isolation and enumeration of Pseudomonas aeruginosa in bottled water, swimming pools and water destined for human consumption.
| Ürün Adı | CN Agar For Pseudomonas |
| Ürün Kodu | BM19608 |
| Miktar | 120 Petri plates Ø 55 mm |
| Ürün Adı | CN Agar For Pseudomonas |
| Ürün Kodu | BK165HA |
| Miktar | 500 g |
| Ürün Adı | CN Agar For Pseudomonas |
| Ürün Kodu | BM14508 |
| Miktar | 20 Petri plates Ø 55 mm |